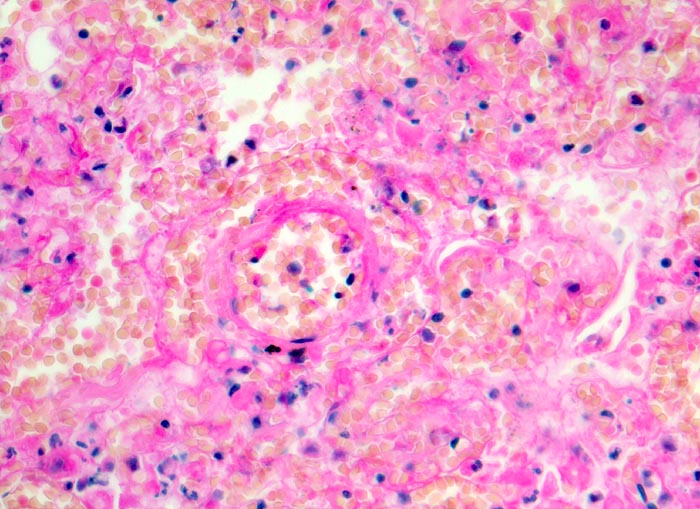

PathoPic – image database / PathoPic ID 3566 - hämorrhagischer Lungeninfarkt
de
Diagnose
hämorrhagischer Lungeninfarkt
Diagnose Gruppe
vaskulär / Durchblutungsstörung
Topographie
Lunge
Topographie Gruppe
Lunge, Mediastinum mit Thymus
Beschreibung
Das Lungengerüst ist nur noch schattenhaft erkennbar. Die Kerne der nekrotischen Zellen sind stark abgeblasst. Das nekrotische Parenchym ist blutig durchtränkt.
Klinik
Tiefe Beinvenenthrombosen bei metastasierendem Prostatakarzinom. Koronare Herzkrankheit.
Bilder Typ
Histologie
Vergrösserung
320
Alter
86
Geschlecht
männlich
Datum
Ersteintrag: 17.12.2001